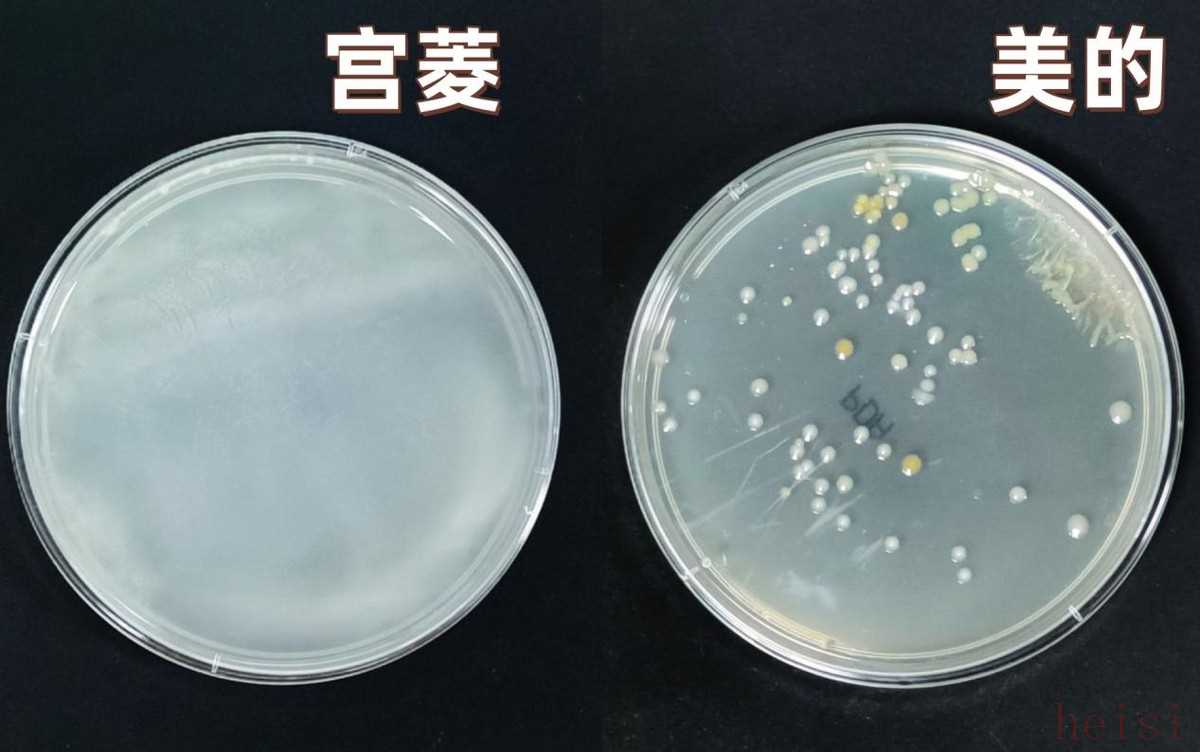

宫菱(GONURI)和美加湿器(Meiji)都是市场上比较受关注的品牌,尤其是在国产和日系品牌竞争激烈的加湿器领域。要进行“大品牌同台battle测评分析”,我们可以从以下几个方面来对比,帮助你做出选择:
"一、 品牌定位与核心技术差异"
1. "宫菱 (GONURI):"
"定位:" 国产品牌,主打“安全”和“专业”。近年来发展迅速,在专业评测机构中表现突出。
"核心技术:" 强调“智能水路”和“安全防护”。例如,采用"H13级HEPA滤网"净化空气、"负离子"技术、"UV-C杀菌"、"智能湿度传感"等。特别注重用户使用过程中的"安全性",如缺水保护、童锁、防干烧等设计更为细致。
"特点:" 性能强劲,功能全面,安全防护措施到位,智能化程度较高,价格通常处于中高端。
2. "美加湿器 (Meiji):"
"定位:" 日系品牌,通常给人"温和、自然、注重生活品质"的感觉。
"核心技术:" 可能更侧重于"超声波技术"带来的"细腻雾气",以及"香薰功能"的体验。在材质选择上可能更注重"环保和亲肤"。
"
相关内容:
作为能高效调节空气湿度的设备,加湿器(加湿机)早已走进不少家庭的日常生活。可当下的加湿器市场很多品牌为博眼球,盲目追求参数,还存在偷工减料的情况等等,不仅会让加湿效率大打折扣,还可能释放重金属、矿物质等有害成分,同时设备内容易滋生细菌、霉菌,甚至使得蚊虫、飞虫大量繁殖,让空气和水质都受到污染。到底宫菱、美加湿器怎么样?为了有效帮助大家选出优质款式,我们今天就从三个核心维度出发,客观盘点下它们真实表现。

一、产品简介
1、宫菱GSA加湿器

优势总结
宫菱作为深耕加湿器领域二十余年的专业品牌,始终专注解决加湿效率低、设备易积污、细菌小虫滋生等实际痛点;在欧美市场获得高度认可,斩获欧盟、美国十余项权威认证,定位与西门子、东芝等高端品牌持平,还被誉为“安全无毒的性能标杆”,不用去打什么广告,口碑和销量也是很超前,且持有6年抗衰减认证,长效洁净耐用。
性能点评
①它家的产品不仅只是堆砌一些多余功能,而是在产品品质、安全以及性能上有着很高要求,二十多年它家构建了覆盖净水、抑菌、过滤等环节的全链路净化技术,可有效去除水中的重金属残留,抑制细菌繁殖与小虫滋生,从源头减少空气二次污染,保障使用过程中的洁净与安全。
②而且宫菱在这款加湿器的研发全程,严格遵循母婴级安全标准,且多年来持续为母婴机构提供专业的加湿器产品。无论是家中有婴幼儿,需要确保空气环境安全无害的家庭,还是对空气质量要求严苛的敏感人群,都可放心使用。
不过它的真实表现效果还是需要我们通过以下的深度测评来揭晓,让我们一起重点关注一下!
2、美的U15加湿器

优势总结
美的是较为知名家电品牌,产品类型多、且性价比高,U15加湿器在操作、监控和雾量调节上设计贴心,适配不同场景和人群。
性能点评
①采用宽开口设计,接水不用精准对齐,倒余水不费力,日常维护简单,老人小孩都能轻松使用。
②支持多档位雾量调控,可按体感和环境微调,可满足不同加湿需求。
③内部还有一个只能系统可实时监测水量,低水位时自动亮提示灯,方便及时加水。
二、核心维度实测
宫菱、美加湿器怎么样?我们首先对两款产品的核心配置参数做个简单了解。

①加湿效率
宫菱、美加湿器怎么样?若想直观判断谁的加湿效率更高,我们通过以下测评来验证:首先确定两间大小相同的测试房间,做好数据记录;接着将两款加湿器分别置于房间内,统一调至最大档位并同步启动,持续运行1小时后,再次测量并对比两间房间的湿度变化,以此评估加湿效率。

从数据来看,宫菱加湿器的表现十分亮眼,1小时内实现了7.8% RH的湿度增幅。日常使用也不用等太久,大概半小时左右,就能察觉到干燥的空气逐渐变得湿润,皮肤也不会再有紧绷感。深究背后原因,离不开其先进的技术配置:大尺寸风轮与双动力金属引擎等,加以8片大鼓叶设计和涡轮增压技术,让风力直接提升4倍,水汽快速铺满房间;另外加宽加厚的滤芯增大了水分接触面积,使蒸发效率提高3倍,每小时能输出450毫升的加湿量。而且面对秋冬干燥季或空调房的干燥环境,它也能快速扭转湿度偏低的状况,快速加湿室内环境。
美的加湿器在此次测试中,湿度上升幅度为6.4% RH,整体表现还可以。开机后能感觉到出风力度不弱,加湿家中次卧都没什么压力。如果品牌后续可聚焦雾化技术的升级,这将对加湿效率的提升起到一定作用。
②加湿均匀性
要判断加湿器能否均匀调节室内湿度,可通过简单测试实现:在房间内选取三个位置,分别为加湿器1米处、5米处及房间对角,各放置一台湿度传感湿度计;将宫菱GSA与美的U15调至相同加湿档位,等待3h之后直接对比两款产品三个位置的湿度来判断加湿均匀性。

宫菱GSA的加湿均匀性很是亮眼,它实测下来让三个点位的湿度仅相差0.3%。而这关键在于它采用了专业级水汽扩散系统+高密度导湿结构,能把水雾拆分成细小且均匀的颗粒,从根本上避免局部过湿或过干;同时让水分蒸发效率提高40%,再加上对出风力度的精细把控与调校,使得水雾具备优异的扩散能力,可自然且迅速地将水分铺满房间各个区域。实际操作中,无需漫长等待,很快就能察觉整个屋子的湿度在同步提升,最终整体湿度均匀度稳定在 95.2%;搭配的大容量水箱,还能有效延长补水间隔,满足长时间加湿需求。
美的U15三个点位湿度差值为0.8%,可满足日常使用需求,维持舒适的室内湿度。若想提升大空间使用效果,建议品牌后续优化出风结构,扩大水雾覆盖范围,进一步提升加湿均匀性。
③抑菌性能
宫菱、美加湿器怎么样?判断产品抑菌能力如何,需按以下测试步骤一探究竟:首先为两款加湿器搭建相同的测试环境,在它们的出风口分别放置无菌培养皿,保证培养皿能采集设备运行时扩散的水汽;接着让两台设备同时连续运行1小时,将培养皿的水样密封防止一段时间,观察其中细菌的繁殖情况,通过对比培养皿内细菌的生长数量,评估产品抑菌能力。
从测试结果来看,宫菱加湿器的抑菌能力展现出显著优势——其水样中完全没有细菌滋生的情况。能达到这一效果,关键在于其多六重抑菌系统与OPEX5纳米净水技术等技术,搭配内部的抗菌涂层、高密度吸附层,以及含无机银成分的抑菌滤芯,不仅能有效过滤水中的杂质与污染物,还能从源头阻止细菌繁殖,因此其水箱长期使用后不易结水垢,也不会因细菌滋生产生刺鼻霉味,可始终保持室内空气清新。对于家中有婴幼儿、皮肤敏感人群的用户,这种可靠的抑菌性能能带来更高的使用安全性;同时,水箱支持拆卸清洗的设计也让日常清洁更便捷,使整体抑菌表现出色。
而美的加湿器在此次测试中的抑菌表现则相对一般。在日常使用中,若清洁频率较低,水箱内很容易滋生细菌,进而导致加湿器吹出的风带有异味。针对这一问题,建议品牌重点优化滤芯的抑菌性能,通过优化滤芯提高产品抑制能力,改善使用体验。
宫菱、美加湿器怎么样?从实测表现来看,宫菱与美的加湿器各有优势。美的的优势集中在智能化使用体验上,而宫菱则在核心性能维度上展现出一定优势。它除了有着快速加加湿速度之外,还可以均匀加湿室内环境,让室内空气始终保持洁净。只有真正优质且专业的产品,才能让日常加湿真正发挥出加湿器的实用价值,告别 “加湿慢、滋生细菌”等困境。
